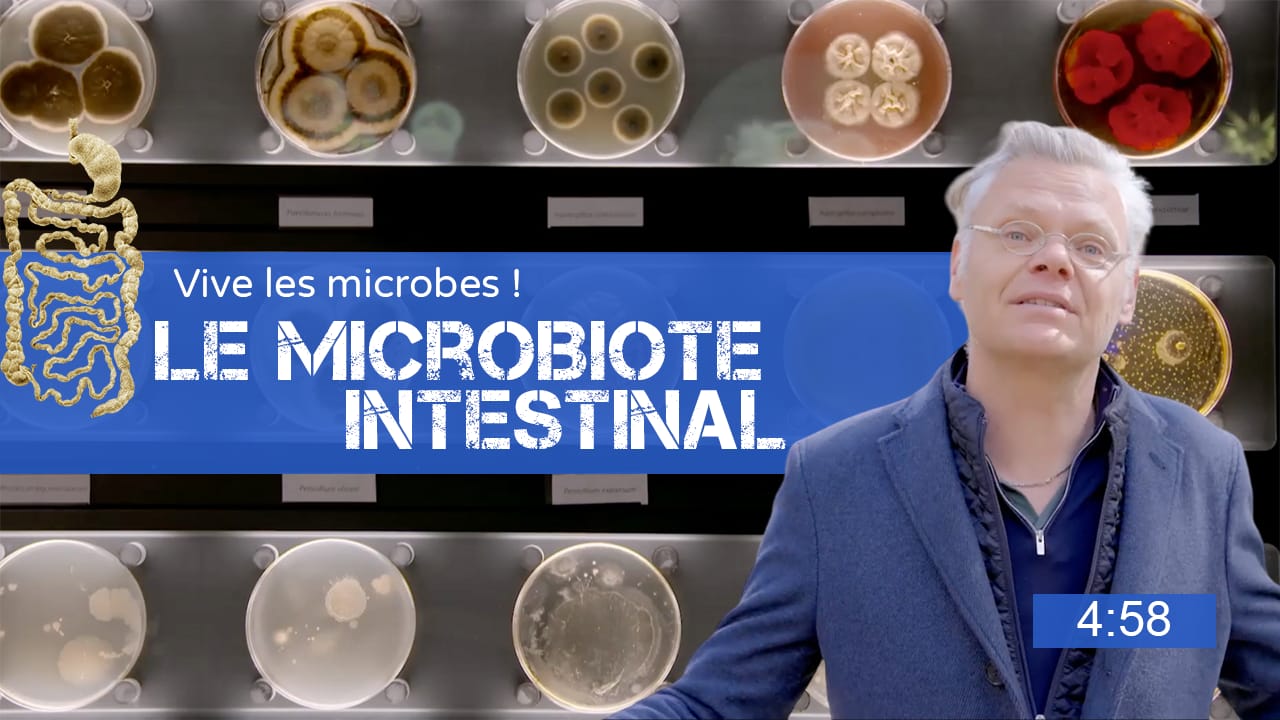

COVID-19, maladie de Lyme, dengue, Ébola, sida, chikungunya, Nipah...
le nombre des "maladies infectieuses émergentes" a explosé au cours des cinquante dernières années.
Les scientifiques, comme les écologues de la santé, pointent les activités anthropiques, qui détruisent la biodiversité, et menacent la santé des écosystèmes, des animaux et des humains.
Un service écosystémique encore méconnu, "l'effet dilution", montre que la biodiversité protège la santé, en régulant le risque de maladie.
Qu'est ce que la biodiversité ?
La biodiversité - végétale, animale, microbienne - désigne la variété des formes de vie sur la terre.
A quoi sert la biodiversité ?
La biodiversité rend de nombreux services écosystémiques à l'humanité, y compris dans le domaine de la santé.
Quel est l’impact des activités humaines ?
Les humains dégradent les écosystèmes par certaines de leurs activités.
Quels sont les facteurs d’émergence des pandémies ?
Les scientifiques ont identifié des facteurs d'émergence communs à de nombreuses épidémies récentes.
Comment protéger la santé planétaire ?
Préserver la biodiversité est le meilleur antidote contre l'émergence de pandémies.